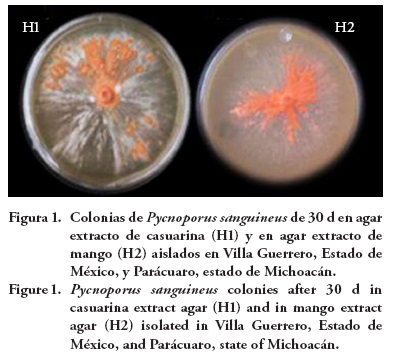

Servicios Personalizados
Revista
Articulo
Indicadores
-
Citado por SciELO -
Accesos
Links relacionados
-
Similares en
SciELO
Compartir
Agrociencia
versión On-line ISSN 2521-9766versión impresa ISSN 1405-3195
Agrociencia vol.49 no.4 Texcoco may./jun. 2015
Biotecnología
Producción de pigmentos de Pycnoporus sanguineus en medio de cultivo sólido
Pycnoporus sanguineus pigment production on solid media
Rocío Cruz Muñoz1*, Ana B. Piña-Guzmán1, Jorge Yáñez-Fernández1, Gustavo Valencia-Del Toro1, Silvia Bautista-Baños2, Ramón Villanueva Arce1
1 Unidad Profesional Interdisciplinaria de Biotecnología (UPIBI), Instituto Politécnico Nacional (IPN). Laboratorio de Biotecnología Alimentaria. 07340. Avenida Acueducto s/n, Barrio La Laguna Ticomán, México. *Autor responsable. (rocum@hotmail.com) (rarce@ipn.mx).
2 Centro de Desarrollo de Productos Bióticos (CeProBi), IPN. Km 8.5 Carretera Yautepec-Jojutla.
Recibido: julio, 2014.
Aprobado: abril, 2015.
Resumen
Pycnoporus es un género representativo de los homobasidiomicetos saprofitos y tiene un potencial lignocelulítico. Los metabolitos secundarios de este hongo son importantes en la búsqueda de sustancias antivirales, antioxidantes, antifúngicas, y antibacterianas. Por lo tanto, el objetivo de este estudio fue evaluar el crecimiento y la producción del pigmento de P. sanguineus en cuatro medios de cultivo sólido, para lo cual se usaron basidiocarpos de P. sanguineus obtenidos de material vegetal en descomposición de árboles de casuarina (H1) y mango (H2). El diseño experimental fue completamente al azar con un arreglo factorial de tratamientos donde los factores y niveles fueron: 1) medio de cultivo (agar papa dextrosa, agar extracto de malta, agar harina integral de trigo, agar extracto de casuarina, y agar extracto de mango); y 2) pH (7.0, 8.0 y 9.0). El estudio duró 30 d y se determinaron las condiciones de crecimiento y producción del pigmento naranja del hongo. Las variables de respuesta fueron diámetro de la colonia (mm), velocidad específica de crecimiento (h-1), concentración del pigmento naranja (mg mL-1) y cantidad de pigmento extraído (mg). Con los datos se realizó una ANDEVA y las medias se compararon mediante contrastes ortogonales (p≤0.05, 0.01, 0.001). Las condiciones óptimas de crecimiento para el aislamiento H1 fueron: agar extracto de casuarina a pH 7.0 y 9.0; y para H2 fue agar extracto de mango a pH 7.0. La mayor velocidad de crecimiento en ambos casos fue en el medio de cultivo con el extracto de donde fueron aislados. Las mayores concentraciones del pigmento se obtuvieron en agar papa dextrosa y agar extracto de malta con 0.0175 y 0.0168 mg mL-1 para H1 y H2 (p≤0.05), respectivamente. La mayor cantidad de pigmento se extrajo en agar papa dextrosa y agar extracto de mango pH= 7.0 de 55.6 y 57.1 mg, para H1 y H2, respectivamente (p≤0.05).
Palabras clave: Pycnoporus sanguineus, actividad biológica, Casuarina equisetifolia, Mangifera indica, biocolorante, fenoxacina.
Abstract
Pycnoporus is a representative genus of saprophytic homobasidiomycetes that has lignocellulytic potential. The secondary metabolites of this fungus have gained importance in the search for antiviral, antioxidant, antifungal and antibacterial substances. Therefore, the objective of this study was to evaluate P. sanguineus growth and production of pigment in four solid media. Basidiocarps from P. sanguineus obtained from decomposing plant material of casuarina (H1) and mango (H2) trees were used. The experimental design was completely randomized with a factorial arrangement of treatments in which the factors and levels were: 1) culture medium (potato dextrose agar, malt extract agar, whole-wheat flour agar, casuarina extract agar and mango extract agar) and 2) pH (7.0, 8.0 and 9.0). The 30-day study determined the fungus growing conditions and production of orange pigment. The response variables were colony diameter (mm), specific growth rate (h-1), concentration of orange pigment (mg mL-1) and quantity of extracted pigment (mg). With the data, an ANOVA was performed and the means were compared by orthogonal contrasts (p≤0.05, 0.01, 0.001). The optimum conditions for growth of the H1 isolate were casuarina extract agar at pH 7.0 and 9.0, whereas for the H2 isolate, they were mango extract agar at pH 7.0. The fastest growth rate in both cases occurred in the culture mediums of extracts from which they were isolated. The highest concentrations of pigment were obtained in potato dextrose agar and malt extract agar, 0.0175 and 0.0168 mg mL-1 for H1 and H2 (p≤0.05), respectively. The largest quantity of pigment was extracted in potato dextrose agar and mango extract agar pH=7.0, 55.6 and 57.1 mg, for H1 and H2, respectively (p≤0.05).
Key words: Pycnoporus sanguineus, biological activity, Casuarina equisetifolia, Mangifera indica, biocolorants, phenoxacine.
INTRODUCCIÓN
Los hongos producen una amplia gama de productos derivados del metabolismo secundario (Calvo et al., 2002), como antibióticos, enzimas y colorantes (Villanueva-Arce et al., 2013). Hay casi 75 000 especies de hongos filamentosos conocidas, pero es probable que sean más de cinco millones (Blackwell, 2011). Las especies de hongos pertenecientes al género Monascus son productores potenciales de pigmentos naturales (Carvalho et al., 2007; Domínguez-Espinosa et al., 2002). Los hongos basidiomicetos producen pudriciones blancas en la naturaleza y forman un grupo ecológico importante (Lomascolo et al., 2011). De éstos, las especies del género Trametes son las más eficientes degradadoras de lignina por su producción de las enzimas lignolitícas (Cilerdzic et al., 2011) lacasa, peroxidasa manganasa, peroxidasa lignina, celobiosa deshidrogenasa y 2-oxidasa piranosa (Nyanhongo et al., 2007).
Algunas especies de hongos de la familia Polyporaceae degradan madera, producen pigmentos, generalmente derivados de ácidos polipóricos y terpenilquinones (Velísek y Cejpek, 2011). De esta familia, Pycnoporus es un género representativo de los homobasidiomicetos saprófitos que tienen un potencial lignocelulítico (Alexopoulos et al., 1996) el cual se vincula con el género Trametes por sus caracteres similares, excepto el color rojo brillante característico de Pycnoporus (Ryvarden, 1991). Según Lomascolo et al. (2011), hay cuatro especies de este género: P. cinnabarinus, P. puniceus, P. sanguineus y P. coccineus. Los pigmentos rojos o anaranjados característicos de los cuerpos fructíferos (basidiocarpos) de este hongo son compuestos derivados de la cinabarina (ácido cinabarínico y la tramesanguina) (Eggert et al., 1996).
Las especies del género Pycnoporus producen pigmentos y tienen potencial biotecnológico por su poder lignocelulítico y por la producción de lacasas, tirosinasas, celobiosadeshidrogenasas, quinasas, invertasas y xilasas (Lomascolo et al., 2011). Por ello aumenta la búsqueda de compuestos antivirales, antioxidantes, antifúngicos, y antibacterianos en los metabolitos secundarios de este hongo (Hwang et al., 2004). En Brasil se usan los basidiocarpos de P. sanguineus como antihemorrágicos (Rosa et al., 2003). Las lacasas reducen el efecto de la dermatitis y ayudan a disminuir lesiones de la piel provocadas por hiedra venenosa (Madhavi y Lele, 2009). Smânia et al. (2003) analizaron la actividad antiviral de los extractos crudos de P. sanguieneus contra el virus de la rabia, y mostraron que no causa lesión sistémica detectable o la muerte en animales. Además, Borderes et al. (2011) observaron actividad antioxidante a los metabolitos secundarios de los extractos de P. sanguineus. Respecto al control de enfermedades causadas por hongos fitopatógenos, los extractos acuosos y metanólicos de P. sanguineus se usan como agentes de biocontrol contra hongos de los géneros Trametes, Lentinus, Microporus, Gloeophyllum y Eariella, los cuales dañan a los árboles de caucho y causan pérdidas económicas en la elaboración de artículos (Teoh et al., 2011).
Los principales compuestos producidos por P. sanguineus son poliporin, cinnabarina, ácido cinabarínico y tramesanguina (Rosa et al., 2003; Acosta-Urdapilleta et al., 2010). El poliporin afecta bacterias Gram positivas y Gram negativas, sin efectos tóxicos en animales de experimentación (Rosa et al., 2003). La cinnabarina es un pigmento naranja con una estructura básica 3-fenoxazina, con un grupo carbonilo en C-1, un grupo amino en C-2 y un grupo hidroxilo en C-9 (Achenbach et al., 1991 y Gripenberg, 1951). Tiene actividad antibiótica contra Bacillus cereus, Enterococcus faecalis, E. faecium, Escherichia coli, Klebsiella pneumoniae, Listeria mesenteroides, Lactobacillus plantarum, Pseudomonas aeruginosa, Salmonella sp., S. typhi, Staphylococcus aureus y Streptococcus spp., así como una mayor actividad antibiótica contra bacterias Gram positivas que negativas (Smânia et al. 1995, 1997). Por lo tanto, el objetivo de este estudio fue evaluar el crecimiento y la producción del pigmentos de P. sanguineus en cuatro medios de cultivo sólido.
MATERIALES Y MÉTODOS
Material biológico
De enero a septiembre del 2010 se recolectaron muestras de material vegetal en descomposición con presencia de cuerpos fructíferos (basidiocarpos) de hongos basidiomicetos saprófitos. Los basidiocarpos del primer aislamiento (H1) se obtuvieron de árboles de casuarina (Casuarina equisetifolia L.) en el Ejido de la Finca, Villa Guerrero, Estado de México (18° 53' 07" N, 99° 37' 36" O, 1839 msnm). El segundo aislamiento (H2), se obtuvo de árboles de mango (Mangifera indica L.) en Parácuaro, estado de Michoacán (19° 08' 44" N, 102° 13' 09" O, 600 msnm). Los basidiocarpos recolectados se llevaron al Laboratorio de Inocuidad Alimentaria de la Unidad Profesional Interdisciplinaria de Biotecnología, Instituto Politécnico Nacional (México, D. F.).
Aislamiento, purificación e identificación de Pycnoporus sanguineus
Del interior de los basidiocarpos se tomó una pequeña muestra de tejido y se trasladó a medio de cultivo agar papa dextrosa (PDA) (BD Bioxon®, México). Las cajas petri inoculadas se incubaron 35 d a 25 ±3 °C. Una vez desarrollado el hongo, se realizaron resiembras hasta su purificación completa. La identificación y caracterización se realizó a nivel molecular, para lo cual se enviaron dos muestras de colonias puras (punta de hifa) al laboratorio de la Estación Nacional de Epidemiología Cuarentena y Saneamiento Vegetal en Querétaro, Querétaro, para la extracción del ADN ribosomal, y su amplificación, secuenciación y alineación con las bases de datos del banco de genes del Centro Nacional para la Información Biotecnológica (NCBI, EE.UU.).
Producción del pigmento de Pycnoporus sanguineus en medio de cultivo sólido
Para determinar las condiciones óptimas de crecimiento y producción del pigmento de P. sanguineus en medio de cultivo sólido, se usó un diseño experimental completamente al azar con un arreglo factorial de tratamientos donde los factores y niveles evaluados fueron: 1) medio de cultivo [agar papa dextrosa, agar extracto de malta (EMA), agar harina de trigo integral (HTIA), agar extracto de casuarina (ECA), para H1; y 2) agar extracto de mango (EMaA) para H2]; y 2) pH (7.0, 8.0 y 9.0).
En este experimento, discos (5 mm de diámetro) de PDA con micelio de cultivos de 30 d de edad de ambos aislamientos fueron depositados en el centro de cajas petri (100 mm de diámetro) con 25 mL de medio de cultivo. Las cajas inoculadas se incubaron 30 d a temperatura ambiente (23± 3 °C) con luz blanca continua (850 lm). Cada tratamiento tuvo cinco repeticiones. Las variables de respuesta fueron: diámetro de colonia (mm); velocidad específica de crecimiento (μ; calculada como r=r0 eμt, r es el radio en mm, t es tiempo en horas y μ es velocidad específica de crecimiento, según Baumer et al. (2008); concentración del pigmento naranja (mg mL-1); y cantidad de pigmento extraído (mg). El crecimiento de la colonia se midió cada día hasta los 30 d; y la concentración y cantidad del pigmento se determinaron al finalizar el tratamiento (30 d).
Al finalizar el período de evaluación, el medio sólido se secó en un horno de convección HCM-A45 (TecniLab Equiment, México) a 35± 2 °C por 14 d. Después se agregaron 50 mL de acetato de etilo sobre la superficie de la capa seca de agar y se raspó hasta obtener el pigmento producido por el hongo. Este extracto reposó 4 d en oscuridad, se tomó una muestra del pigmento extraído y se midió la absorbancia a 490 nm en un espectrofotómetro Lambda XLS (Perkin Elmer, EE.UU.). Para determinar la concentración del pigmento (mg mL-1), se realizó una curva tipo con concentraciones conocidas del colorante químico rojo de metilo (Sigma-Aldrich, MA, EE.UU.) y la concentración de pigmento se calculó con la ecuación de regresión obtenida (y=107.19x+0.0001). La cantidad de pigmento extraído se determinó por diferencia de masas (mg) de la capa seca de agar antes y después del proceso de extracción. Las muestras secas se colocaron en viales y se almacenaron a temperatura ambiente (23± 3 °C) hasta su uso.
Con los extractos en acetato de etilo se realizó una cromatografía de capa fina para comparar los frentes de retención (Rf) del pigmento producido por los aislamientos de P. sanguineus con el colorante rojo de metilo. Las muestras se colocaron en una placa cromatográfica 60 F254 (Merck®, Alemania), y tratadas con acetato de etilometanol (1:2) como fase móvil. Además, se hizo un barrido espectrofotométrico en una longitud de onda de 200 a 700 nm del pigmento obtenido. Finalmente, se leyó la absorbancia de alícuotas de 400 μL de cada muestra (extractos H1 y H2) diluídas con 400 μL de acetato de etilo en un espectrofotómetro Lambda XLS (Perkin Elmer, EE.UU.).
Análisis estadístico de datos
Los resultados se analizaron mediante ANDEVA y las medias de los tratamientos (efectos principales) se compararon por medio de contrastes ortogonales (p≤0.05, 0.01, 0.001). Para estos análisis se usó SAS (Versión 9.0 para Windows).
RESULTADOS Y DISCUSIÓN
Aislamiento, purificación e identificación de Pycnoporus sanguineus
Los aislamientos (H1 y H2) de P. sanguineus aislados (Figura 1) presentaron un crecimiento de la colonia variable. En el aislamiento H1, el hongo cubrió con micelio blanco toda la superficie del medio de cultivo de la caja petri a los 10-15 d (5.38.0 mm d-1), mientras que el aislamiento H2 lo hizo a los 10-12 d (6.7-8.0 mm d-1). La morfología de las colonias y de los basidiocarpos concuerda con lo reportado por Papinutti (2013) para la especie P. sanguineus. Esto se comparó con los resultados de la caracterización molecular (Cuadro 1) de la región intergénica ITS1 del ADN ribosomal y su alineamiento con las bases de datos del Banco de Genes del NCBI, y mostró 98 % de identidad y un índice de similaridad de 787, para el aislamiento H1, y para el aislamiento H2 fue 97 % de identidad y un índice de similaridad de 822. Ambos fueron comparados con el aislamiento 7IV2/2 de P. sanguineus con número de acceso GQ982886 (Cuadro 1).
Producción de pigmento de Pycnoporus sanguineus en medio de cultivo sólido
Los aislamientos H1 y H2 de P. sanguineus cubrieron toda la caja petri a los 13 d después de la siembra (dds). Estos datos difieren con lo reportado por Baumer et al. (2008) quienes observaron que las cepas MIP 95001, MIP 95002 y MIP 20001 de P. sanguineus llenaron las cajas petri 5 ddd pero el diámetro del disco de inóculo inicial fue 14 mm.
Respecto al diámetro de las colonias, el medio de cultivo y pH evaluados tuvieron un efecto significativo en los dos aislamientos y las mejores condiciones para el crecimiento de las colonias fueron: 1) para H1, agar extracto de casuarina con una velocidad de crecimiento radial de 6.1 mm d-1 y pH 7.0 y 9.0 (velocidad de crecimiento de 4.8 mm d-1 y 4.7 mm d-1, respectivamente); 2) para H2, agar extracto de mango, pH 7.0, y una velocidad de crecimiento radial de 6.1 mm d-1, y 4.6 mm d-1, respectivamente (Cuadros 2 y 3). Esto se debe a una afinidad por las fuentes de donde ellos fueron aislados.
Acosta-Urdapilleta et al. (2010) probaron los mismos medios de cultivo, excepto los extractos de casuarina y mango, en el crecimiento de cepas de P. sanguineus (HEMIM-52, HEMIM-53 y HEMIM-54) y reportan un crecimiento característico del hongo pero sin diferencia significativa entre los medios PDA y HTIA para la producción de biomasa. Además, Smânia et al. (1998) muestran condiciones de cultivo para la cepa MIP 89007 de P. sanguineus en caldo papa, pH 9.0 y 25 °C bajo luz por 20 d. En nuestro estudio, el crecimiento de los aislamientos H1 y H2 (Figura 1) en extractos de casuarina y mango agar de 30 d mostraron una pigmentación menor al obtenido en PDA (Figura 2).
De acuerdo con la afinidad mostrada por los aislamientos del hongo sobre los extractos del material del cual fueron aislados, las mayores velocidades específicas del crecimiento a los 3, 5 y 10 d se presentaron en el ECA para el aislamiento H1, mientras que para H2 fue EMaA (Cuadros 2 y 3). En H1, durante los primeros días no hubo diferencias entre ECA y HTIA. En todos los casos, las velocidades para H1 y H2 fueron menores a las reportadas por Baumer et al. (2008) para las cepas MIP 95002 (μ = 0.0164 h-1) y MIP 95001 y 20001 (μ=0.0147 y 0.0145 h-1, respectivamente) en PDA.
En el aislamiento H1 las mayores concentraciones del pigmento producido así como la cantidad total extraída, se presentaron en el medio de cultivo PDA y EMA sin importar el pH (Cuadro 2), mientras que para el aislamiento H2 lo fue en PDA y pH indistinto (Cuadro 3). Lo anterior muestra que las mayores velocidades de crecimiento del hongo, no de manera necesaria, implican una mayor producción del pigmento naranja. Esto coincide con Baumer et al. (2008), quienes mencionan que el crecimiento micelial, no de manera obligatoria, está relacionado con la producción de metabolitos secundarios (cinabarina). Además, de acuerdo con los datos de concentración y pigmento extraído, no hay correlación entre el colorante químico rojo de metilo con el colorante naranja producido por el hongo, porque las cantidades del pigmento extraído rebasan la cantidad estimada (debería ser 50 veces la concentración estimada). Esto puede significar que la cantidad total extraída contiene otros pigmentos o componentes que fueron arrastrados por el acetato de etilo (Figura 3).

Según Acosta-Urdapilleta et al. (2010), el mejor sustrato para producir cinnabarina en primordios fue pino, seguido por encino y cedro sin importar la cepa utilizada. El contenido promedio del pigmento cinnabarina en primordios del hongo fue 56 mg g-1 y no hubo diferencias entre la cinnabarina producida por los cuerpos fructíferos bien desarrollados (basidiocarpos) que fue 68 mg g-1. La ventaja de usar los cuerpos fructíferos es obtener hasta dos o más cosechas, pero se requieren 242 a 356 d.
La producción de la cinnabarina, perteneciente al grupo de las fenoxacinas, puede realizarse in vitro en medios sólidos y líquidos, o bien in vivo con la producción de basidiocarpos. En nuestro estudio los resultados pueden ser menores que los reportados pero las ventajas principales fueron menor tiempo y facilidad en el manejo. Según Acosta-Urdapilleta et al. (2010), los metabolitos primarios y secundarios producidos por el género Pycnoporus son diferentes y dependen de la especie y condiciones de cultivo. El pigmento anaranjado producido por P. sanguineus puede tener aplicaciones importantes dentro de las industrias alimentaria, farmacéutica o biotecnológica por su actividad biológica: antiviral, antioxidante, antifúngica, y antibacteriana; además de la importancia en la industria de los biocolorantes obtenidos de fuentes biológicas. La disponibilidad y el uso de colorantes naturales han aumentado debido a las preferencias de los consumidores por colorantes de origen natural con respecto a los sintéticos que imparten sabores indeseables y son perjudiciales a la salud; además, la acción legislativa ha excluido a los colorantes artificiales (Rymbai et al., 2011).
El frente de retención (Rf) obtenido por cromatografía de capa fina con los extractos de P. sanguineus con respecto al rojo de metilo fue 0.83 (Figura 4). Acosta-Urdapilleta et al. (2010) reportan una curva tipo con cinnabarina a 265 nm (y=0.235x+0.398) con concentraciones de 2 a 10 mg mL-1 del extracto acuoso de P. sanguineus; y además de la cinnabarina detectaron el ácido cinabarínico. La cromatografía de capa fina de H1 y H2 se efectuó con los eluyentes hexano:acetato 2:1, y los resultado fueron para H1 Rf= 0.77, y para H2 0.33, 0.77 y 0.88 (Figura 4). Smânia et al. (1995) realizaron cuatro fraccionamientos de los extractos de este hongo y reportan valores de RfFA=0.78, RfFB = 0.54, RfFC = 0.48 y RfFD= 0.78; la fracción FB contenía 3-1 fenoxacina como componente principal detectado a 264 nm. El barrido de los extractos de los aislamientos de P. sanguineus se hizo con acetato de etilo de 200 a 700 nm. Este intervalo se usó porque hay compuestos como la cinnabarina y 3-1 fenoxacina con una absorbancia de 265 y 264 nm, según Restrepo (2007), y mostró una relación de las longitudes de onda y los colores percibidos: amarillo (565-590nm), naranja (590-625 nm) y rojo (625-740 nm). Los extractos de H1 y H2 se perciben a simple vista en este rango de colores. Para H1 hubo picos a 214, 266, 431 y 450 nm; y 228, 257, 431 y 451 nm para H2 (Figura 3). Esto coincide con lo reportado por Acosta-Urdapilleta et al. (2010), quienes encontraron una banda característica de cinnabarina a 265 nm y el barrido con acetato de etilo mostró otros pigmentos a 290, 400, 440 y 450 nm.
Lo anterior implica que los extractos obtenidos en nuestro estudio están conformados por varios pigmentos anaranjados, resultados similares a los de Méndez-Zavala et al. (2007) quienes reportan dos picos a 505 y 425 nm en el barrido de 400 a 600 nm del pigmento rojo producido por Penicillium purpurogenum. Según Domínguez-Espinosa et al. (2002), hay una combinación de dos o más pigmentos que van del amarillo al naranja (405 nm) y de pigmentos rojos (495 nm) en los pigmentos de Monascus. Esto concuerda con Carvalho et al. (2007) quienes mencionan que al avanzar la fermentación de Monascus, se producen pigmentos rojos-amarillos, pero los pigmentos rojos también absorben luz a 400 nm. Como ya se indicó, es posible que los extractos obtenidos en nuestra investigación estén conformados por una mezcla de varios pigmentos que están en la misma longitud de onda (264 y 265 nm), y también hay otros que van de rojo a naranja y son generados por el grupo fenoxacina.
CONCLUSIONES
La producción de pigmentos y crecimiento in vitro de Pycnoporus sanguineus en medios de cultivo con agar fue viable porque hubo extracción mayor de los pigmentos. En los pigmentos obtenidos por el aislamiento H1 de P. sanguineus, la mayor producción fue en agar papa dextrosa, mientras que para H2 fue en agar extracto de mango. El crecimiento de P. sanguineus y la extracción de los pigmentos anaranjados en estos medios de cultivo tiene ventajas, como la reducción de la cantidad de medio utilizada (25 mL), además de la facilidad de manejo y almacenamiento de las muestras.
AGRADECIMIENTOS
Cruz-Muñoz agradece al Consejo Nacional de Ciencia y Tecnología (CONACyT) por el apoyo económico otorgado para la realización de sus estudios de posgrado. Además, se agradece a la Subdirección de Investigación y Posgrado (proyectos 20113692, 20120572, 20131830), y a la Comisión de Operación y Fomento de Actividades Académicas del Instituto Politécnico Nacional (IPN-COFAA) por el apoyo económico otorgado para la realización de este estudio.
LITERATURA CITADA
Achenbach, H., and E. Blümm. 1991. Investigation of the pigments of Pycnoporus sanguineus -picnosanguin and new phenoxazin-3-ones. Arch. Pharm. 324: 3-6. [ Links ]
Acosta-Urdapilleta, L., G. A. Alonso-Paz, A. Rodríguez, M. Adame, D. Salgado, M. Montiel-Peña, F. Medrano-Vega, y E. C. Villegas-Villarreal. 2010. Pycnoporus sanguineus, un hongo con potencial biotecnológico In: Martínez-Carrera, D., N. Cuvetto, M. Sobal, P. Morales, y V. M. Mora (eds). Hacia un Desarrollo sustentable de Producción-Consumo de los Hongos Comestibles y Medicinales en Latinoamérica: Avances y Perspectivas en el siglo XXI. Puebla. 2010. Red Latinoamericana de Hongos Comestibles y Medicinales. COLPOS-UNS-CONACYT-AMC-UAEM-UPAEP-IMINAP. pp: 531-562. [ Links ]
Alexopoulos C. J., C. W. Mims, and M. Blackwell. 1996. Phylum Basidiomycota order Aphyllophorales, polypores, Chantharelles, tooth fungi, coral fungi and corticioids. In: Harris, D. (ed). Introductory Mycology 4th Ed. New York, U. S. A. Wiley and Sons Inc. pp: 563-597. [ Links ]
Baumer, J. D., S. M. Mas Diego, S. M. V. Pacheco, A. F. M. Morgado, and A. F. Jr. Furigo. 2008. Comparative study of mycelial growth and production of cinnabarin by different strains of Pycnoporus sanguineus. Biofar Rev. Biol. Farm. 2:1-5. [ Links ]
Blackwell, M. 2011. The fungi: 1, 2, 3...5.1 million species? Am. J. Bot. 98: 426-438. [ Links ]
Borderes, J., A. Costa, A. Guedes, and T. L. B. Ballod. 2011. Antioxidant activity of the extracts from Pycnoporus sanguineus mycelium. Braz. Arch. Biol. Technol. Int. J. 54: 1167-1174. [ Links ]
Calvo, A. M., R. A. Wilson, J. Woo-Bok, and N. P. Keller. 2002. Relationship between secondary Metabolism and fungal development. Microbiol. Mol. Biol. Rev. 66: 447-459. [ Links ]
Carvalho, J. C., B. O. Oishi, A.L. Woiciechowski, A. Pandey, S. Babitha, and C. R. Soccol. 2007. Effect of substrates on the production of Monascus biopigments by solidstate fermentation and pigment extraction using different solvents. Indian J. Biotechnol. 6: 194-199. [ Links ]
Cilerdzic, J., M. Stajic, J. Vukojevic, S. Duletic-Lausevic, and A. Knezevic. 2011. Potential of Trametes hirsuta to produce ligninolytic enzymes during degradation of agricultural residues. BioRes. 6: 2885-2895. [ Links ]
Domínguez-Espinosa, R. M., R. Wang, y J. D. Pacho-Carrillo. 2002. Residuos agroindustriales como materia prima para la producción de compuestos químicos finos. Tecnol. Ciencia Ed. (IMIQ) 17: 77-83. [ Links ]
Eggert, C., U. Temp, and K. E. L. Eriksson. 1996. The lignolytic system of the white-rot fungus Pycnoporus cinnabarinus: purification and characterization of the laccase. Appl. Environ. Microbiol. 62: 1151-1158. [ Links ]
Gripenberg, J. 1951. Fungus pigment. I. Cinnabarin, a colouring matter from Trametes cinnabarina Jacq. Acta Chem. Scand. 12: 590-59. [ Links ]
Hwang, H. J., S. W. Kim, C. P. Xu, J. W. Choi, and J. W. Yun. 2004. Morphological and rheological properties of the three different species of basidiomycetes Phellinus in submerged cultures. Appl. Microbiol. Biotechnol. 96: 1296-1305. [ Links ]
Lomascolo, A., E. Uzan-Boukhris, I. Herpoël-Gimbert, J. C. Sigoillot, and L. Lesage-Meessen. 2011. Peculiarities of Pycnoporus species for applications in biotechnology. Appl. Microbiol. Biotechnol. 92: 1129-1149. [ Links ]
Madhavi, V., and S. S. Lele. 2009. Laccase properties use. BioRes. 4: 1694-1717. [ Links ]
Méndez-Zavala, A., J. C. Contreras-Esquivel, F. Lara-Victoriano, R. Rodríguez-Herrera, y C. N. Aguilar. 2007. Producción fúngica de un pigmento rojo empleando la cepa xerofilica Penicillium purpurogenum GH-2. Rev. Mex. Ing. Quím. 6: 267-273. [ Links ]
Nyanhongo, G. S., G. Gübitz, P. Sukyai, C. Leitner, D. Haltrich, and R. Ludwing. 2007. Oxidoreductases from Trametes spp. in Biotechnology: a wealth of catalytic activity. Food Technol. Biotechnol. 45: 250-268. [ Links ]
Papinutti, L. 2013. Pycnoporus sanguineus. Fichas Micológicas. Rev. Boletín Biol. 7: 31-32. [ Links ]
Restrejo G.M. 2007. Sustitución de colorantes en alimentos. Rev. Lasallista Investig. 4: 35-39. [ Links ]
Rosa, L. E., M. K. M. Gomes, J. C. Cristina, M. Capelari, R. C. Augusto, and Z. C. Leomar. 2003. Screening of Brazilian basidiomycetes for antimicrobial activity. Mem. Inst. Owaldo Cruz 98: 967-974. [ Links ]
Rymbai, H., R. R. Sharma, and Manish Srivastav. 2011. Biocolorants and its implications in health and food industry- A review. Int. J. Pharm. Tech. Res. 3: 2228-2244. [ Links ]
Ryvarden, L. 1991. Genera of polypores, nomenclature and taxonomy. Syn. Fungorum. 5: 1-373. [ Links ]
Smânia, A. Jr., C. J. S. Marques, E. F. A. Smânia, C. R. Zanetti, S. G. Carobrez, R. Tramonte, and C. Loguercio-Leite. 2003. Toxicity and antiviral activity of cinnabarin obtained from Pycnoporus sanguineus (Fr.) Murr. Phytother Res. 17: 1069-1072. [ Links ]
Smânia, A. Jr., F. Delle -Monache, E. F. A. Smânia, M. L. Gil, L. C. Benchetrit, and F. S. Cruz. 1995. Antibacterial activity of a substance produced by the fungus Pycnoporus sanguineus (Fr.) Murr. J. Ethnopharmacol. 45: 177-181. [ Links ]
Smânia, E. F. A., A. Jr. Smânia, C. Loguercio-Leite, and M. L. Gil. 1997. Optimal parameters for cinnabarin synthesis by Pycnoporus sanguineus. J. Chem. Biotechnol. 70: 57-59. [ Links ]
Smânia, E. F. A., A. Jr. Smânia, and L.C. Loguercio. 1998. Cinnabarin synthesis by Pycnoporus sanguineus strains and antimicrobial activity against bacteria from food products. Rev. Microbiol. 29: 129-136. [ Links ]
Statistical Analysis System, Version 9.0 for Windows. 2002. SAS User's Guide: Statistics. Release 6.1 Copyright© 1995-2002 by SAS Institute Inc., Cary, NC, USA. [ Links ]
Teoh, Y. P., M.M. Don, and S. Ujang. 2011. Media selection for mycelia growth, antifungal activity against wood-degrading fungi, and Gc-Ms study by Pycnoporus sanguineus. BioRes. 6: 2719-2731. [ Links ]
Velísek, J., K. Cejpek. 2011. Pigments of higher fungi: A review. Czech J. Food Sci. 29: 87-102. [ Links ]
Villanueva-Arce, R., C. A. Aguilar-Pompa, Y de las M. Gómez y Gómez, G. Valencia del Toro, A. B. Piña-Guzmán, y S. Bautista-Baños. 2013. Control de las bacterias patógenas y hongos de postcosecha con extractos del pigmento de Gibberella zeae (Fusarium graminearum). Agrociencia 47: 691-705. [ Links ]













